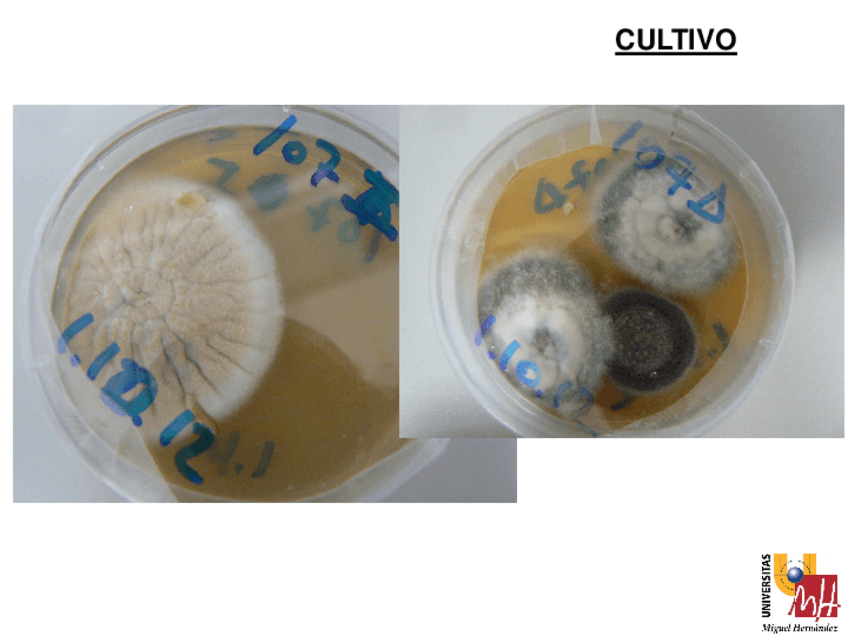
Miniatura del documento T7-Dermatomicosis-2013-14-4.pdf

T7-Dermatomicosis-2013-14.pdf
66 páginas

Normativa-seminarios-Quiropodologia-1-2013-14.pdf
3 páginas

.articulo-arrastrado.pdf

Instrumental-quiropodologico-2013-14.ppt

Normativa-seminarios-Quiropodologia-1-2013-14.pdf
3 páginas

T7-Dermatomicosis-2013-14-1.pdf
13 páginas

T7-Dermatomicosis-2013-14-2.pdf
13 páginas

T7-Dermatomicosis-2013-14-3.pdf
13 páginas
T7-Dermatomicosis-2013-14-4.pdf
13 páginas

T7-Dermatomicosis-2013-14-5.pdf
13 páginas

T7-Dermatomicosis-2013-14-6.pdf
1 página
content_copy